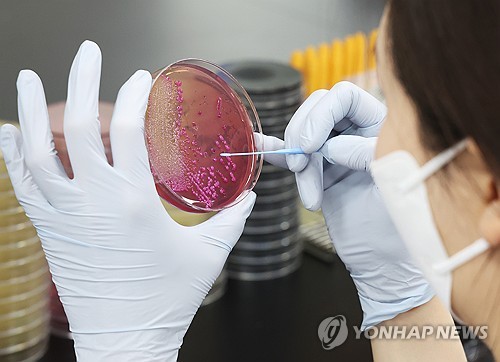
<em class='find'해외 온라인카지노 벳무브</em 호텔서 투숙객 잇따라 구토·설사 호소…당국, 역학조사

통합검색
해외 온라인카지노 벳무브 1,907
-
 고위공직자 절반 정도가 '다주택자'…42채 가진 공직자는?
고위공직자 절반 정도가 '다주택자'…42채 가진 공직자는?했고, 용산구(74채)가 뒤를 이었습니다. 조성명 강남구청장[서울 강남구 제공][서울 강남구 제공] 조사 대상 중 가장 많은 주택을 보유한 공직자는 총 42채를 보유한 조성명 서울 강남구청장이었습니다. 본인 명의 강남구 아파트 1채, 고양시 오피스텔 38채"
2025-11-18 08:01:40 -
 특정 의약품 사용 대가로 20억 챙긴 병원장 부부...나란히 징역형 확정
특정 의약품 사용 대가로 20억 챙긴 병원장 부부...나란히 징역형 확정리베이트 의사(CG)[자료 이미지][자료 이미지] 특정 제약사 의약품을 납품받는 대가로 20억 원에 달하는 뒷돈을 챙긴 병원장 부부가 실형을 확정받았습니다. 오늘(17일) 법조계에 따르면 대법원은 배임수재 및 의료법 위반 혐의로 구속기소 된 강원 속초"
2025-11-17 14:16:58 -
속초 호텔서 투숙객 잇따라 구토·설사 호소…당국, 역학조사
속초 호텔서 투숙객 잇따라 구토·설사 호소…당국, 역학조사강원 속초 한 호텔에서 투숙객들이 식중독 의심 증세를 보여 보건 당국이 역학조사에 나섰습니다. 식중독균 배양분리작업[연합해외 온라인카지노 벳무브 자료사진][연합해외 온라인카지노 벳무브 자료사진] 어제(15일) 오후 10시 27분쯤 속초"
2025-11-16 14:23:53 -
![[해외 온라인카지노 벳무브] 제주는 취나물 수확철](https://yonhapnewstv-prod.s3.ap-northeast-2.amazonaws.com/article/MYH/20251115/MYH20251115134906JSd.jpg) 온라인카지노 라이센스 벳무브온라인카지노
온라인카지노 라이센스 벳무브온라인카지노취나물은 향긋한 맛으로 겨울 밥상에 오르며 제철의 풍미를 더하겠네요. <2> 두 번째 사진입니다. 찬 바람이 불기 시작한 동해안에는 겨울의 전령사, 양미리가 찾아왔습니다. 강원 속초시 동명동에 한 오징어 난전 부두에는 그"
2025-11-15 13:49:33 -
 저승 다스리는 마지막왕…70여년 만에 한국 품으로
저승 다스리는 마지막왕…70여년 만에 한국 품으로[앵커] 6·25 전쟁 후 미국으로 불법 반출됐던 조선시대 불화가 70여년 만에 한국으로 돌아왔습니다. 저승에서 망자를 심판하는 열명의 왕 중 마지막 열번째 왕, 전륜대왕을 그린 속초 신흥사 시왕도가 주인공입니다. 서형석"
2025-11-14 14:45:08
디지털기획물
‘속초’에 대한 디지털기획물 검색 결과가 없습니다.
![[탐사보도 해외 온라인카지노 벳무브프리즘] 의정 갈등 1년째 공회전…위태로운 의료 현장과 환자들](https://yonhapnewstv-prod.s3.ap-northeast-2.amazonaws.com/article/MYH/20250301/MYH20250228220000703_P1.jpg)

![[해외 온라인카지노 벳무브] 동해안 '겨울 별미' 양미리 조업 시작 外](https://yonhapnewstv-prod.s3.ap-northeast-2.amazonaws.com/vod/20231112/1699833110566ehN1O.jpg)
![[풍경여지도] 추석특집 팔도음식 열전 - 2부 바다 편](https://yonhapnewstv-prod.s3.ap-northeast-2.amazonaws.com/article/MYH/20230929/MYH20230927013200641_P1.jpg)
